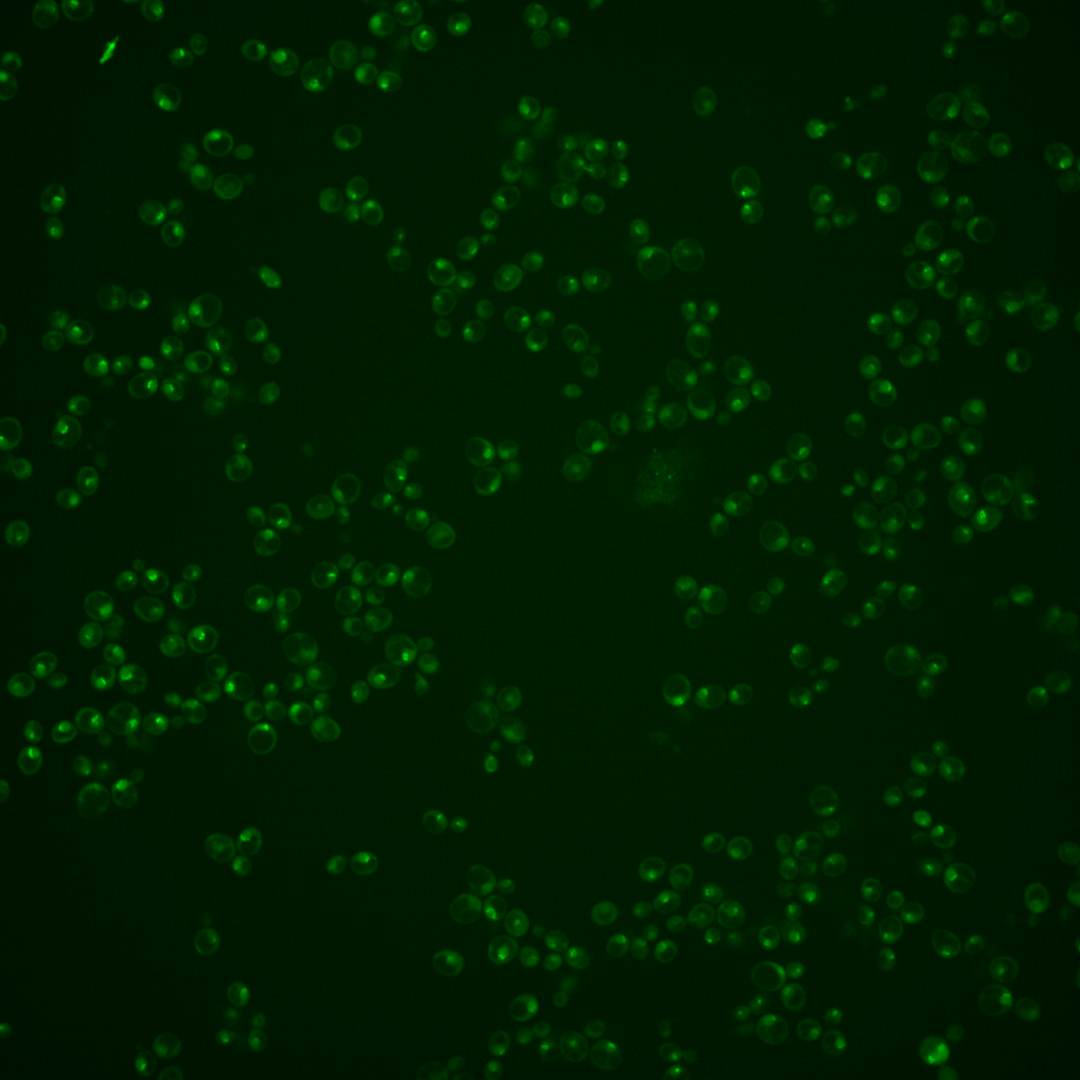
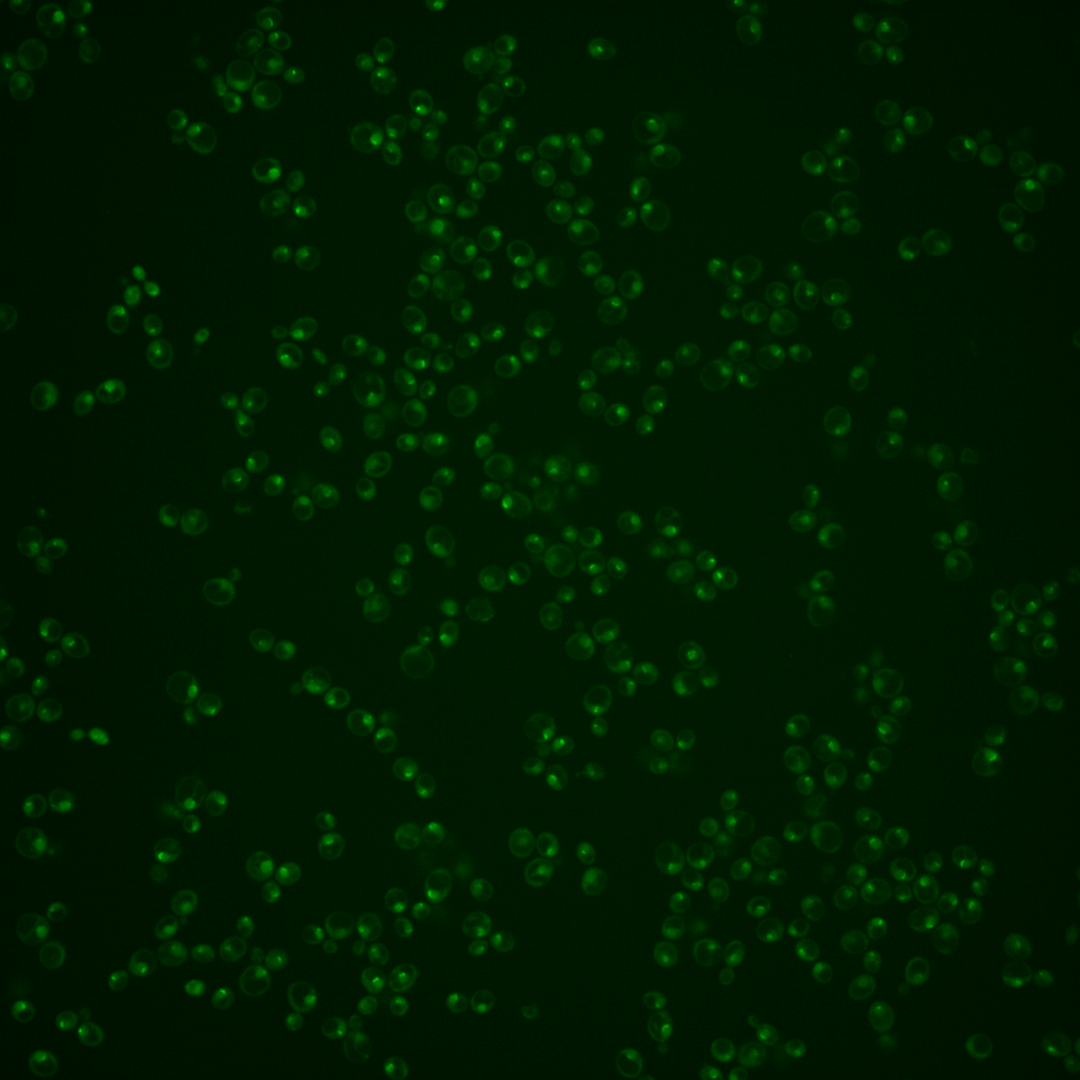
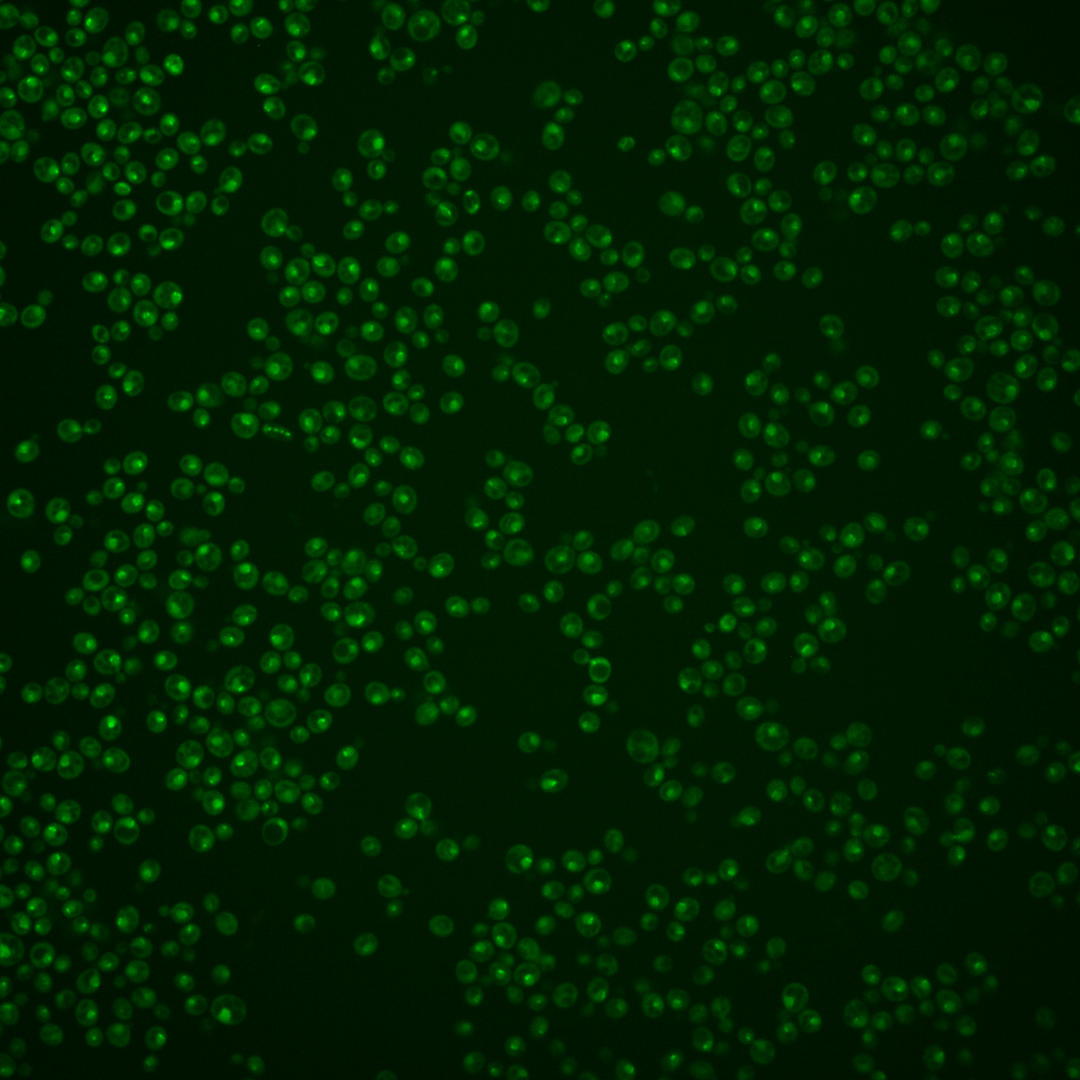
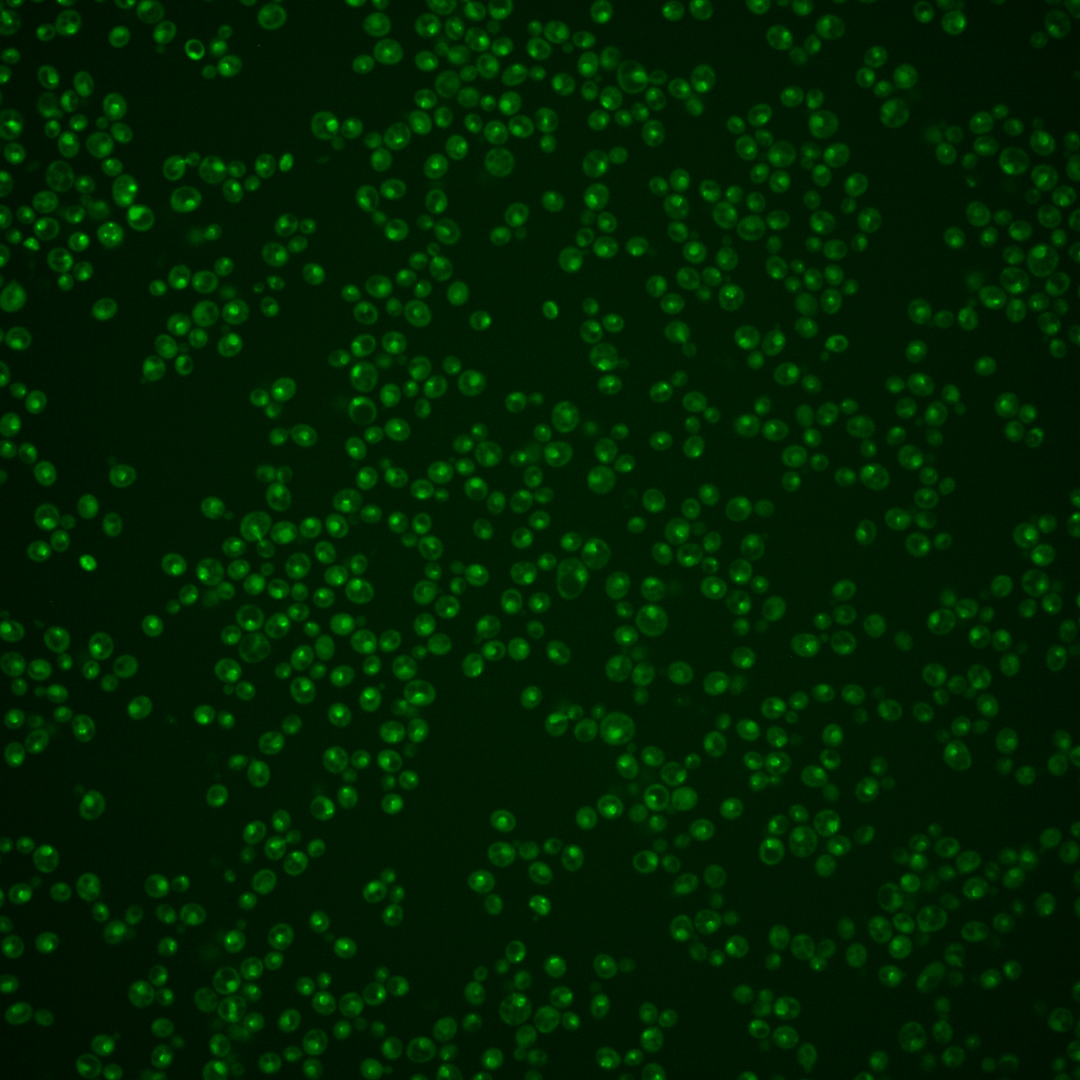

| Standard name | |
|---|---|
| Human Ortholog | |
| Description | Protein required for transcription of rDNA by RNA polymerase I; transcription factor independent of DNA template; involved in recruitment of RNA polymerase I to rDNA; structure reveals unique HEAT repeat fold and a surface serine patch; phosphorylation of serine patch impairs cell growth and reduces RNA polymerase I binding in vitro and RNA polymerase I recruitment to the rDNA gene in vivo |
Micrographs




















































































Sub-cellular Localization
Yeast GFP Assignment
Protein Abundance
Localization Change
External localization resources
| ensLOC | DeepLoc | |||||||||||||||||||||||
|---|---|---|---|---|---|---|---|---|---|---|---|---|---|---|---|---|---|---|---|---|---|---|---|---|
| Localization | WT1 | WT2 | WT3 | RAP60 | RAP140 | RAP220 | RAP300 | RAP380 | RAP460 | RAP540 | RAP620 | RAP700 | HU80 | HU120 | HU160 | rpd3Δ_1 | rpd3Δ_2 | rpd3Δ_3 | WT1 | WT2 | WT3 | AF100 | AF140 | AF180 |
| Cortical Patches | 0 | 0 | – | 0 | 0 | 0 | 0 | – | 0 | 0 | 0 | 0 | 0 | 0 | 0 | 0 | 0 | 0 | 0 | 0 | 0 | 0 | 0 | 0 |
| Bud | 0 | 0 | – | 0 | 0 | 2 | 3 | – | 2 | 6 | 1 | 4 | 0 | 0 | 0 | 1 | 1 | 0 | 0 | 0 | 1 | 0 | 2 | 0 |
| Bud Neck | 0 | 0 | – | 0 | 7 | 4 | 10 | – | 0 | 4 | 0 | 5 | 0 | 0 | 3 | 0 | 1 | 0 | 0 | 0 | 0 | 0 | 3 | 2 |
| Bud Site | 0 | 0 | – | 0 | 0 | 4 | 5 | – | 1 | 4 | 5 | 6 | 0 | 0 | 0 | 1 | 1 | 1 | – | – | – | – | – | – |
| Cell Periphery | 0 | 0 | – | 0 | 0 | 0 | 0 | – | 0 | 1 | 0 | 0 | 0 | 1 | 0 | 0 | 0 | 1 | 0 | 0 | 0 | 0 | 0 | 0 |
| Cytoplasm | 0 | 6 | – | 2 | 28 | 33 | 46 | – | 10 | 28 | 9 | 19 | 3 | 34 | 31 | 19 | 8 | 12 | 0 | 0 | 1 | 2 | 4 | 9 |
| Endoplasmic Reticulum | 1 | 0 | – | 0 | 5 | 0 | 4 | – | 0 | 0 | 1 | 5 | 0 | 2 | 1 | 4 | 0 | 2 | 0 | 0 | 0 | 0 | 1 | 0 |
| Endosome | 2 | 41 | – | 1 | 17 | 19 | 13 | – | 2 | 6 | 4 | 6 | 1 | 20 | 17 | 35 | 26 | 19 | 11 | 22 | 7 | 4 | 26 | 29 |
| Golgi | 0 | 1 | – | 0 | 0 | 0 | 0 | – | 0 | 0 | 0 | 0 | 0 | 0 | 0 | 1 | 0 | 0 | 0 | 2 | 0 | 0 | 1 | 0 |
| Mitochondria | 30 | 10 | – | 1 | 4 | 22 | 33 | – | 46 | 51 | 92 | 103 | 2 | 1 | 0 | 22 | 9 | 11 | 0 | 0 | 0 | 1 | 4 | 3 |
| Nucleus | 20 | 68 | – | 14 | 20 | 22 | 39 | – | 17 | 33 | 27 | 33 | 8 | 34 | 14 | 15 | 12 | 9 | 7 | 23 | 4 | 5 | 12 | 7 |
| Nuclear Periphery | 1 | 0 | – | 0 | 0 | 0 | 0 | – | 0 | 0 | 0 | 1 | 0 | 0 | 0 | 0 | 0 | 0 | 0 | 1 | 0 | 0 | 0 | 2 |
| Nucleolus | 38 | 94 | – | 0 | 0 | 1 | 6 | – | 1 | 7 | 2 | 2 | 11 | 9 | 1 | 37 | 26 | 15 | 24 | 99 | 18 | 23 | 38 | 22 |
| Peroxisomes | 0 | 0 | – | 0 | 0 | 0 | 0 | – | 0 | 0 | 0 | 0 | 0 | 0 | 1 | 1 | 2 | 1 | 0 | 0 | 0 | 0 | 0 | 0 |
| SpindlePole | 15 | 68 | – | 5 | 28 | 26 | 49 | – | 11 | 39 | 9 | 29 | 1 | 46 | 28 | 39 | 26 | 17 | 28 | 88 | 9 | 24 | 67 | 36 |
| Vac/Vac Membrane | 2 | 2 | – | 0 | 15 | 19 | 5 | – | 3 | 4 | 8 | 3 | 0 | 4 | 4 | 13 | 10 | 9 | 4 | 3 | 2 | 0 | 17 | 13 |
| Unique Cell Count | 69 | 205 | 19 | 114 | 128 | 171 | 73 | 135 | 113 | 160 | 24 | 125 | 87 | 116 | 74 | 58 | 80 | 249 | 47 | 66 | 186 | 140 | ||
| Labelled Cell Count | 109 | 290 | 23 | 124 | 152 | 213 | 93 | 183 | 158 | 216 | 26 | 151 | 100 | 188 | 122 | 97 | 80 | 249 | 47 | 66 | 186 | 140 | ||
Yeast GFP Assignment
Protein Abundance
| Screen | WT1 | WT2 | WT3 | RAP60 | RAP140 | RAP220 | RAP300 | RAP380 | RAP460 | RAP540 | RAP620 | RAP700 | HU80 | HU120 | HU160 | rpd3Δ_1 | rpd3Δ_2 | rpd3Δ_3 | AF100 | AF140 | AF180 |
|---|---|---|---|---|---|---|---|---|---|---|---|---|---|---|---|---|---|---|---|---|---|
| Mean Cell GFP Intensity (1e-4) | 4.1 | 5.8 | – | 5.6 | 5.7 | 4.5 | 4.7 | – | 3.7 | 4.2 | 3.6 | 3.6 | 5.2 | 5.6 | 5.3 | 7.7 | 7.5 | 7.4 | – | 5.5 | 5.5 |
| Std Deviation (1e-4) | 0.5 | 0.9 | – | 2.1 | 1.7 | 1.4 | 2.1 | – | 1.0 | 1.3 | 1.3 | 1.0 | 0.7 | 1.5 | 1.3 | 2.3 | 1.8 | 2.5 | – | 1.2 | 1.2 |
| Intensity Change (Log2) | – | – | – | – | – | – | – | – | – | – | – | – | – | – | – | – | – | – | – | – | – |
Localization Change
| Localization | RAP60 | RAP140 | RAP220 | RAP300 | RAP380 | RAP460 | RAP540 | RAP620 | RAP700 | HU80 | HU120 | HU160 | rpd3Δ_1 | rpd3Δ_2 | rpd3Δ_3 |
|---|---|---|---|---|---|---|---|---|---|---|---|---|---|---|---|
| Actin | – | – | – | – | – | – | – | – | – | – | – | – | – | – | – |
| Bud | – | – | – | – | – | – | – | – | – | – | – | – | – | – | – |
| Bud Neck | – | – | – | – | – | – | – | – | – | – | – | – | – | – | – |
| Bud Site | – | – | – | – | – | – | – | – | – | – | – | – | – | – | – |
| Cell Periphery | – | – | – | – | – | – | – | – | – | – | – | – | – | – | – |
| Cyto | – | – | – | – | – | – | – | – | – | – | – | – | – | – | – |
| Endoplasmic Reticulum | – | – | – | – | – | – | – | – | – | – | – | – | – | – | – |
| Endosome | – | – | – | – | – | – | – | – | – | – | – | – | – | – | – |
| Golgi | – | – | – | – | – | – | – | – | – | – | – | – | – | – | – |
| Mitochondria | – | – | – | – | – | – | – | – | – | – | – | – | – | – | – |
| Nuclear Periphery | – | – | – | – | – | – | – | – | – | – | – | – | – | – | – |
| Nuc | – | – | – | – | – | – | – | – | – | – | – | – | – | – | – |
| Nucleolus | – | – | – | – | – | – | – | – | – | – | – | – | – | – | – |
| Peroxisomes | – | – | – | – | – | – | – | – | – | – | – | – | – | – | – |
| SpindlePole | – | – | – | – | – | – | – | – | – | – | – | – | – | – | – |
| Vac | – | – | – | – | – | – | – | – | – | – | – | – | – | – | – |
| Cortical Patches | – | – | – | – | – | – | – | – | – | – | – | – | – | – | – |
| Cytoplasm | – | – | – | – | – | – | – | – | – | – | – | – | – | – | – |
| Nucleus | – | – | – | – | – | – | – | – | – | – | – | – | – | – | – |
| Vacuole | – | – | – | – | – | – | – | – | – | – | – | – | – | – | – |
External localization resources
Images






























Protein Concentration and Protein Localization Data
| R1 | R2 | R3 | ||||||||||||||||
|---|---|---|---|---|---|---|---|---|---|---|---|---|---|---|---|---|---|---|
| G1 Pre-START | G1 Post-START | S/G2 | Metaphase | Anaphase | Telophase | G1 Pre-START | G1 Post-START | S/G2 | Metaphase | Anaphase | Telophase | G1 Pre-START | G1 Post-START | S/G2 | Metaphase | Anaphase | Telophase | |
| Concentration | -0.2497 | 0.0814 | -0.3004 | -0.7879 | -0.3375 | -0.4864 | -0.0722 | 0.539 | 0.2617 | 0.0968 | -0.0653 | 0.2046 | -0.8511 | -0.3276 | -0.6041 | -0.6234 | -0.4581 | -0.8544 |
| Actin | 0.0391 | 0 | 0.0041 | 0.0035 | 0.0013 | 0.0002 | 0.0145 | 0.0001 | 0.0037 | 0.0009 | 0.002 | 0.0002 | 0.0149 | 0.0001 | 0.0221 | 0.0001 | 0.0203 | 0.0004 |
| Bud | 0.0003 | 0.0001 | 0.0002 | 0.0003 | 0.0003 | 0.0001 | 0.0003 | 0.0002 | 0.0001 | 0.0003 | 0.0001 | 0 | 0.0007 | 0.0001 | 0.0005 | 0.0001 | 0.0003 | 0.0002 |
| Bud Neck | 0.0023 | 0.0018 | 0.0022 | 0.0015 | 0.0043 | 0.0038 | 0.0033 | 0.006 | 0.0034 | 0.0011 | 0.0026 | 0.004 | 0.0034 | 0.0026 | 0.0026 | 0.0076 | 0.0115 | 0.0054 |
| Bud Periphery | 0.0004 | 0.0001 | 0.0003 | 0.0005 | 0.0009 | 0.0001 | 0.0007 | 0.0003 | 0.0006 | 0.0006 | 0.0003 | 0.0001 | 0.0013 | 0.0002 | 0.0008 | 0.0002 | 0.0007 | 0.0003 |
| Bud Site | 0.005 | 0.0009 | 0.0013 | 0.0007 | 0.0017 | 0.0003 | 0.0028 | 0.0027 | 0.0018 | 0.0009 | 0.0006 | 0.0003 | 0.0089 | 0.0029 | 0.0112 | 0.0019 | 0.0017 | 0.0007 |
| Cell Periphery | 0.0004 | 0.0001 | 0.0002 | 0.0001 | 0.0003 | 0.0001 | 0.0004 | 0.0002 | 0.0004 | 0.0001 | 0.0001 | 0.0001 | 0.0008 | 0.0003 | 0.0003 | 0.0003 | 0.0003 | 0.0002 |
| Cytoplasm | 0.0075 | 0.0015 | 0.004 | 0.0002 | 0.0026 | 0.0004 | 0.0062 | 0.0022 | 0.0093 | 0.003 | 0.0005 | 0.0001 | 0.0025 | 0.0015 | 0.0008 | 0.0068 | 0.0036 | 0.0038 |
| Cytoplasmic Foci | 0.0269 | 0.0049 | 0.0175 | 0.0105 | 0.0141 | 0.0053 | 0.0156 | 0.0061 | 0.0092 | 0.0097 | 0.009 | 0.0022 | 0.0125 | 0.0045 | 0.0185 | 0.0075 | 0.0186 | 0.007 |
| Eisosomes | 0.0003 | 0 | 0.0001 | 0.0001 | 0.0001 | 0 | 0.0003 | 0 | 0.0002 | 0.0001 | 0 | 0 | 0.0004 | 0 | 0.0002 | 0 | 0.0002 | 0 |
| Endoplasmic Reticulum | 0.0027 | 0.0009 | 0.0006 | 0.0002 | 0.001 | 0.0001 | 0.0031 | 0.0001 | 0.0009 | 0.001 | 0.0031 | 0.0001 | 0.0018 | 0.0002 | 0.0005 | 0.001 | 0.0025 | 0.0003 |
| Endosome | 0.0243 | 0.0051 | 0.0127 | 0.0172 | 0.0162 | 0.0049 | 0.0319 | 0.0015 | 0.0151 | 0.0233 | 0.024 | 0.003 | 0.0158 | 0.0025 | 0.0162 | 0.0383 | 0.0326 | 0.0025 |
| Golgi | 0.0109 | 0.0004 | 0.0053 | 0.0174 | 0.0073 | 0.0032 | 0.0118 | 0.0007 | 0.0036 | 0.0039 | 0.0089 | 0.0025 | 0.0064 | 0.0007 | 0.0057 | 0.0012 | 0.0108 | 0.0015 |
| Lipid Particles | 0.0562 | 0.013 | 0.0451 | 0.0722 | 0.0753 | 0.0263 | 0.0389 | 0.0179 | 0.0286 | 0.0604 | 0.0656 | 0.0277 | 0.0169 | 0.0189 | 0.037 | 0.0049 | 0.054 | 0.0098 |
| Mitochondria | 0.0208 | 0.0001 | 0.019 | 0.084 | 0.0067 | 0.0126 | 0.0182 | 0.0002 | 0.0042 | 0.012 | 0.0038 | 0.0013 | 0.008 | 0.0004 | 0.0072 | 0.0002 | 0.0039 | 0.0005 |
| None | 0.014 | 0.0147 | 0.0038 | 0.0003 | 0.0204 | 0.0003 | 0.0083 | 0.0014 | 0.0165 | 0.0442 | 0.0006 | 0.0002 | 0.0029 | 0.0096 | 0.0008 | 0.001 | 0.0046 | 0.0013 |
| Nuclear Periphery | 0.0342 | 0.0074 | 0.0268 | 0.0048 | 0.0383 | 0.0141 | 0.0243 | 0.0149 | 0.0155 | 0.0315 | 0.0038 | 0.0018 | 0.0132 | 0.0042 | 0.0033 | 0.0032 | 0.0192 | 0.0067 |
| Nucleolus | 0.3708 | 0.5599 | 0.5948 | 0.458 | 0.4264 | 0.5492 | 0.3624 | 0.5521 | 0.5575 | 0.5018 | 0.5118 | 0.5189 | 0.3871 | 0.5526 | 0.5216 | 0.6195 | 0.3567 | 0.4657 |
| Nucleus | 0.1751 | 0.1914 | 0.1285 | 0.1304 | 0.1354 | 0.1589 | 0.1825 | 0.2305 | 0.2 | 0.1054 | 0.2197 | 0.1625 | 0.2028 | 0.2897 | 0.2002 | 0.1484 | 0.2358 | 0.1727 |
| Peroxisomes | 0.0183 | 0.0002 | 0.0058 | 0.0232 | 0.0338 | 0.002 | 0.0209 | 0.0009 | 0.005 | 0.0089 | 0.0024 | 0.0006 | 0.0084 | 0.0014 | 0.0172 | 0.0003 | 0.0053 | 0.0029 |
| Punctate Nuclear | 0.1853 | 0.1954 | 0.1235 | 0.1712 | 0.1883 | 0.2171 | 0.2462 | 0.16 | 0.1187 | 0.1621 | 0.1388 | 0.2737 | 0.2831 | 0.1048 | 0.128 | 0.1477 | 0.2119 | 0.3169 |
| Vacuole | 0.0032 | 0.0017 | 0.0022 | 0.0019 | 0.0132 | 0.0007 | 0.0057 | 0.0016 | 0.0039 | 0.0151 | 0.0011 | 0.0004 | 0.0063 | 0.0023 | 0.004 | 0.0092 | 0.0045 | 0.0011 |
| Vacuole Periphery | 0.0022 | 0.0002 | 0.0018 | 0.0018 | 0.0121 | 0.0004 | 0.002 | 0.0002 | 0.0018 | 0.0138 | 0.001 | 0.0003 | 0.0019 | 0.0003 | 0.0014 | 0.0007 | 0.0011 | 0.0003 |
Sequencing Data
| R1 | R2 | |||||||||
|---|---|---|---|---|---|---|---|---|---|---|
| G1 Post-START | S/G2 | Metaphase | Anaphase | Telophase | G1 Post-START | S/G2 | Metaphase | Anaphase | Telophase | |
| Gene Expression | 19.62 | 19.8951 | 23.31 | 19.3632 | 19.7431 | 12.8776 | 19.0571 | 19.8294 | 18.1838 | 23.9756 |
| Translational Efficiency | 1.4423 | 1.4689 | 1.0212 | 1.0843 | 1.1827 | 1.8318 | 1.2165 | 0.9798 | 1.0112 | 0.9784 |
Hit Data
| Dataset | Hit |
|---|---|
| Protein Concentration | ✘ |
| Protein Localization | ✘ |
| Gene Expression | ✘ |
| Translational Efficiency | ✘ |
Endocytosis
| Temp | Actin Patch (Sac6-tdTomato) | Cortical Patch (Sla1-GFP) | Late Endosome (Snf7-GFP) | Vacuole (Vph1-GFP) |
|---|---|---|---|---|
| 37℃ | ||||
| RT |
Cell Cycle Omics
CYCLoPs (Rrn3-GFP)
| Gene / Allele | Actin Patch (Sac6-tdTomato) | Cortical Patch (Sla1-GFP) | Late Endosome (Snf7-GFP) | Vacuole (Sac6-tdTomato) |
|---|
| Gene | Images |
|---|
| Gene | Images |
|---|
Images are not yet available
Images are not yet available